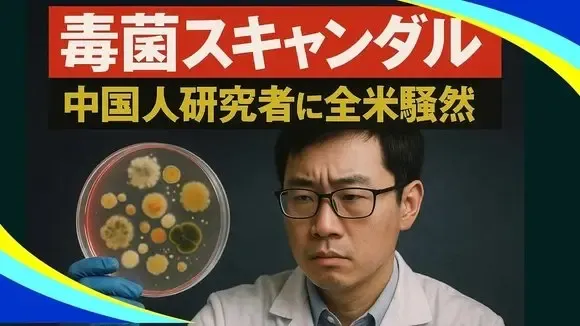
【新視点ニュース】「中共は米国人を狙っている」！？中国人学者、危険菌を米密輸

【新視点ニュース】「中共は米国人を狙っている」!?中国人学者、危険菌を米密輸
もっと見る >日: 2025年7月9日
【中国禁聞】「華為の”核弾頭級”新型ノートが旧世代チップ使用。米の締め付け効果顕著」など【動画】
【中国禁聞】「華為の”核弾頭級”新型ノートが旧世代チップ使用。米の締め付け効果顕著」など
もっと見る >【薇羽看世間】中国貴港の少女が路上で救急車に連れ去られ、翌日には葬儀場へ。悪夢の24時間【動画】
【薇羽看世間】中国貴港の少女が路上で救急車に連れ去られ、翌日には葬儀場へ。悪夢の24時間
もっと見る >